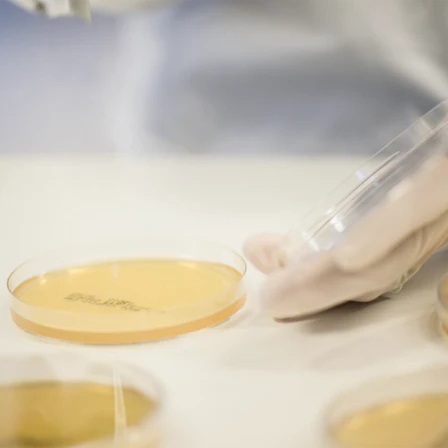

Que sont les probiotiques ?


Tout ce qu’il faut savoir
Les probiotiques* sont des bactéries vivantes et des levures souvent qualifiées de « bonnes bactéries » ou « bactéries amies ». Ces micro-organismes participent à l’équilibre naturel de votre système digestif.
Vous pouvez retrouver ces probiotiques* dans votre alimentation et également dans certains compléments alimentaires.
Zoom sur les probiotiques
Les informations présentées ici sont fournies à titre informatif et ne sauraient se substituer à un avis médical.
Leader mondial des probiotiques
Issus de plus de 30 années de recherche et d’innovation, les compléments alimentaires probiotiques BioGaia® sont de haute qualité, fondés sur la science et s'intègrent facilement dans la routine quotidienne.
Bactéries et santé intestinale
Longtemps considérées comme dangereuses, les bactéries sont aujourd’hui reconnues pour la plupart comme bénéfiques pour notre santé.
Certaines bactéries sont même essentielles à notre survie, tandis qu’une minorité seulement est potentiellement dangereuse.
Quelles actions ont les probiotiques ?
Notre corps abrite des milliards de bactéries de toutes sortes. Elles sont partout : dans notre bouche, dans notre intestin, sur notre peau.
Dans des conditions normales ou "équilibrées", les bactéries bénéfiques du système digestif sont plus nombreuses que les bactéries nocives. Or, les effets d’un mode de vie moderne (stress, antibiotiques, régimes pauvres en fibres) fragilisent cet équilibre.
Un microbiote intestinal sain et équilibré contribue au bien-être général, car près de 80 % de notre système immunitaire se trouve dans l’intestin.

Prébiotiques et probiotiques : quelle est la différence ?
Les prébiotiques sont généralement des fibres qui nourrissent les bactéries de notre intestin, favorisant ainsi leur croissance et leur activité. Considérons les comme le carburant de nos bactéries intestinales.
Les probiotiques*, quant à eux, sont des bactéries vivantes qui vous pouvez consommer dans l’alimentation (comme le yaourt et la choucroute par exemple) et/ou sous forme de compléments alimentaires. Ce sont des bactéries bénéfiques pour notre système digestif.
Ensemble, ils participent à l’équilibre de notre microbiote intestinal.
Quels sont les aliments probiotiques ? Est-il nécessaire de prendre des probiotiques si je consomme des aliments fermentés ?
Les aliments riches en probiotiques, comme les yaourts, le kéfir, la choucroute, le kimchi et d’autres produits fermentés, contiennent des bactéries vivantes. Mais certains de ces aliments sont soumis à des traitements susceptibles de réduire le nombre de ces micro-organismes bénéfiques.
Un complément alimentaire probiotique* de qualité doit nous apporter la garantie que les bactéries vivantes sont présentes en quantité suffisante afin qu’elles puissent jouer leur rôle.
Si les aliments fermentés constituent une source naturelle de micro-organismes intéressants pour votre intestin, les compléments alimentaires probiotiques* peuvent assurer un apport complémentaire en souches spécifiques, à un dosage maîtrisé.

Comment les souches probiotiques sont-elles désignées ?
Les bactéries sont classées par genre, espèce et souche. Et comme chaque souche a son propre matériel génétique, elle possède des caractéristiques spécifiques.
Les souches sont différentes, avec leurs propres effets ; chaque souche est donc unique, comme chacun d’entre nous!
Le terme « bactéries lactiques » est très général. C’est pourquoi il est important de connaître la souche précise, comme le Limosilactobacillus reuteri DSM 17938 (ou L. reuteri Protectis®) - l'une des souches probiotiques de la gamme BioGaia®, pour savoir exactement si le complément alimentaire probiotique* que vous prenez peut vous convenir.
Comprendre les souches probiotiques
Les produits à base de probiotiques* peuvent contenir une ou plusieurs souches avec des concentrations de bactéries qui peuvent varier.
La qualité d’un probiotique dépend des souches spécifiques qu’il contient : certaines doivent être présentes en grandes quantités, et d’autres en moindre grand nombre.
Un complément alimentaire à base de probiotiques* doit contenir exactement les mêmes souches que celles étudiées lors des études cliniques, et aux mêmes doses, pour être considéré comme efficace et sûr.
La gamme complète de produits BioGaia® répond à cette exigence.¹
En savoir plus sur nos souches probiotiques.
Des millions ou des milliards d’UFC, la quantité compte-t-elle ?
L’UFC (Unité Formant Colonie) fournit une estimation du nombre de cellules bactériennes vivantes présentes dans chaque dose, comme dans un comprimé par exemple.
Mais un nombre élevé d’UFC n’est pas forcément corrélé à une meilleure efficacité.
Ce qui fait la différence en matière de probiotiques et d’efficacité, ce sont les études cliniques qui ont été réalisées avec les mêmes quantités de bactéries que celles contenues dans une dose recommandée.
L’étiquetage du complément alimentaire probiotique décrypté

UTILISATION RECOMMANDÉE : description de l’utilisation prévue du produit et des effets attendus.
CONSEILS D’UTILISATION : quantité nécessaire pour obtenir l’effet désiré.
UFC (Unités formant colonie) : nombre de bactéries vivantes contenues dans le produit (parfois désignées « cultures vivantes »). Évitez les produits comportant la mention « au moment de la fabrication », car l’UFC indiqué ne reflétera pas les quantités réelles en fin de durée de conservation. Le nombre d’UFC est généralement indiqué de manière globale, mais il est préférable de le préciser pour chaque souche. L’UFC figurant sur l’étiquette doit correspondre à celui utilisé dans les études scientifiques.
CONSERVATION : informations sur les conditions de conservation du produit pour en préserver la qualité et l’innocuité.
RAISON SOCIALE ET COORDONNÉES : les consommateurs peuvent contacter BioGaia® pour obtenir des réponses à leurs questions ainsi que pour de plus amples renseignements.
GENRE, ESPÈCE ET SOUCHE DES BACTÉRIES : les trois informations sont indispensables pour savoir exactement de quel probiotique* il s’agit. Le savoir est important, car différentes souches au sein d’une même espèce peuvent avoir des effets différents. Choisissez des produits qui précisent bien la ou les souches utilisées.
DATE LIMITE DE CONSOMMATION OPTIMALE: date jusqu’à laquelle le complément alimentaire probiotique* contient encore une quantité suffisante de bactéries vivantes pour produire l’effet attendu. Les probiotiques* sont des micro-organismes vivants dont la quantité peut diminuer pendant la durée de conservation.
Comment bien choisir les probiotiques adaptés à nos besoins ?
Il peut être plus difficile de choisir un complément alimentaire probiotiques* qu’un complément multivitaminé. Les souches ont des noms compliqués qui peuvent déconcerter, et il n’est pas évident de trouver celle qui correspond parfaitement à nos besoins.
Avant de prendre un complément alimentaire probiotique*, il convient déjà de s’assurer que la souche a bien été testée dans le cadre de recherches afin de vérifier son innocuité et que le dosage est suffisant.
Un complément alimentaire probiotique* de qualité doit aussi pouvoir coloniser temporairement notre intestin. C’est cette colonisation qui nécessaire pour participer à l'équilibre de notre microbiote intestinal.
Pour cela, il est nécessaire que les bactéries arrivent vivantes dans le système digestif.
Les études ont montré que toutes les souches probiotiques* contenues dans les compléments alimentaires BioGaia® sont vivantes en atteignant l’intestin.²
International Scientific Association for Probiotics and Prebiotics
Faute de réglementation unifiée dans le domaine des compléments alimentaires probiotiques*, notamment concernant leur efficacité et leur qualité, BioGaia® a choisi d’adhérer à l’International Scientific Association for Probiotics and Prebiotics (ISAPP). Les guides préparés par l’ISAPP pour les consommateurs vous aident à faire le bon choix.
En tant que membres de l’ISAPP, nous nous engageons à proposer de véritables compléments alimentaires probiotiques*.
| Critères | Conformité des probiotiques BioGaia® |
|---|---|
| Efficacité scientifiquement prouvée | ✓ Les souches probiotiques Limosilactobacillus reureti* (L. reuteri) présentes dans les compléments alimentaires* BioGaia® figurent parmi les mieux documentées scientifiquement au monde.³ |
| Dose efficace | ✓ Nos travaux de recherche ont permis de parvenir à un dosage efficace, qui varie d’un produit à l’autre. |
| Bienfaits recherchés obtenus | ✓ Les études ont montré que les souches probiotiques présentes dans les compléments alimentaires* BioGaia® participent à l'équilibre du microbiote intestinal et que le xylitol*** présent dans les compléments alimentaires de la gamme Prodentis® contribue à une bonne santé bucco-dentaire. |
| Tolérance reconnue | ✓ Les souches souches probiotiques* présentes dans les compléments alimentaires BioGaia® ont toutes le statut QPS(Présomption d’Innocuité Reconnue)****. Elles ont été rigoureusement évaluées et leur utilisation alimentaire a été validée par les groupes scientifiques de l’Autorité européenne de sécurité des aliments (EFSA). |
| Étiquetage conforme | ✓ Les étiquettes de nos produits BioGaia® précisent toujours le genre, l’espèce et la souche, en plus d’indiquer le nombre d’UFC en fin de durée de conservation, la dose recommandée, les conditions de conservation et nos coordonnées. |
PLUS IL Y EN A, MIEUX C’EST ?
Pas nécessairement. Un nombre plus élevé d’unités formant colonie (UFC) n’est pas toujours un gage de qualité supérieure. La meilleure dose connue est celle qui a fait l’objet d’études scientifiques rigoureuses. Les niveaux du nombre d'UFC peuvent varier entre 100 millions et plus d’un milliard d’UFC par jour selon la souche.
FAUT-IL PRIVILÉGIER LES PRODUITS MULTI-SOUCHES ?
Fions-nous à ce que dit la science! L’essentiel est que des études rigoureuses aient été menées sur les produits en question pour prouver leur efficacité. Un mélange de plusieurs souches ne garantit en rien l’efficacité supérieure d’un produit. Seules les études cliniques le peuvent.
LA SPÉCIFICITÉ DE LA SOUCHE EST-ELLE IMPORTANTE ?
Les scientifiques s’accordent à dire que tous les probiotiques ne sont pas identiques. Il convient donc de choisir une souche ou une combinaison de souches validée scientifiquement en fonction de l’effet recherché.
TOUS LES ALIMENTS FERMENTÉS SONT-ILS DES ALIMENTS PROBIOTIQUES ?
Les alimentés fermentés ont été transformés sous l’effet de cultures vivantes. Certains sont ensuite soumis à des traitements (comme la pasteurisation) qui peuvent détruire les ferments.
Les aliments fermentés sont sains, mais il se peut qu’ils ne remplissent pas toujours les critères pour mériter
l’appellation de probiotiques, à moins qu’ils ne contiennent un probiotique
étudié, en quantité suffisante.
Les compléments alimentaires probiotiques* contiennent des micro-organismes vivants dont les effets sont prouvés quand ils sont en quantité suffisante.
Nos experts répondent aux questions les plus fréquentes sur les probiotiques !
Les bactéries sont classées par genre, espèce et souche. Les souches probiotiques* d’une même espèce ont des caractéristiques différentes.
L’essentiel est que des études rigoureuses aient été menées sur les produits en question pour prouver leur efficacité.
Les critères importants lors du choix d’un complément alimentaire probiotique* sont les suivants :
Les bactéries probiotiques* doivent être définies au niveau de la souche.
Le complément alimentaire probiotique* commercialisé doit proposer la même dose et les mêmes souches bactériennes que lors des tests cliniques.
Les souches probiotiques* brevetées présentes dans les produits BioGaia® sont initialement des souches d’origine humaine, ce qui signifie qu’elles entrent naturellement dans la composition de notre microbiote intestinal.
Certains autres produits probiotiques* sur le marché contiennent des souches provenant de plantes ou d’animaux, donc n’entrent pas naturellement dans la composition de notre microbiote intestinal.
Le terme microbiote désigne la multitude de micro-organismes (principalement des bactéries, mais aussi des levures, virus et autres microbes) qui peuplent naturellement notre corps. Ces micro-organismes sont particulièrement nombreux dans l’intestin, où ils coexistent avec nous dès la naissance.
Le microbiote constitue un environnement dynamique et complexe où différents types de micro-organismes interagissent entre eux, et avec notre corps.
Le microbiote de chaque personne est unique et influencé par de nombreux facteurs, notamment le régime alimentaire, l’environnement, l’âge et le mode de vie.
Ces dernières années, les scientifiques se sont de plus en plus intéressés à l’interaction de cet écosystème interne avec différents aspects de notre vie.
* Les probiotiques participent à l’équilibre du microbiote intestinal.
Les compléments alimentaires doivent être utilisés dans le cadre d’un mode de vie sain et ne pas être utilisés comme
substituts d’un régime alimentaire varié et équilibré.
Pour plus d’informations, voir étiquetage.
Ne pas dépasser la dose journalière recommandée.
Pour votre santé, évitez de grignoter entre les repas. www.mangerbouger.fr
**International Scientific Association for Probiotics and Prebiotics (ISAPP).
*** La consommation de denrées alimentaires contenant du xylitol à la place de sucre contribue au maintien de la minéralisation des dents.
**** EFSA Panel on Biological Hazards (BIOHAZ) et al. “Update of the list of QPS-recommended biological agents intentionally added to food or feed as notified to EFSA 12: suitability of taxonomic units notified to EFSA until March 2020.” EFSA journal. European Food Safety Authorityvol. 18,7 e06174. 2 Jul. 2020, doi:10.2903/j.efsa.2020.6174doi:10.2903/j.efsa.2023.7746.
¹ Hill, Colin et al. “Expert consensus document. The International Scientific Association for Probiotics and Prebiotics consensus statement on the scope and appropriate use of the term probiotic.” Nature reviews. Gastroenterology & hepatologyvol. 11,8 (2014): 506-14. doi:10.1038/nrgastro.2014.66
² Valeur, Nana et al. “Colonization and immunomodulation by Lactobacillus reuteri ATCC 55730 in the human gastrointestinal tract.” Applied and environmental microbiologyvol. 70,2 (2004): 1176-81. doi:10.1128/AEM.70.2.1176-1181.2004
Frese SA, Hutkins RW, Walter J. Comparison of the colonization ability of autochthonous and allochthonous strains of lactobacilli in the human gastrointestinal tract. Adv Microbiol. 2012;2(3):399–409. doi:10.4236/aim.2012.23047.
³ Selon le nombre d’articles, PubMed Avr. 2024.